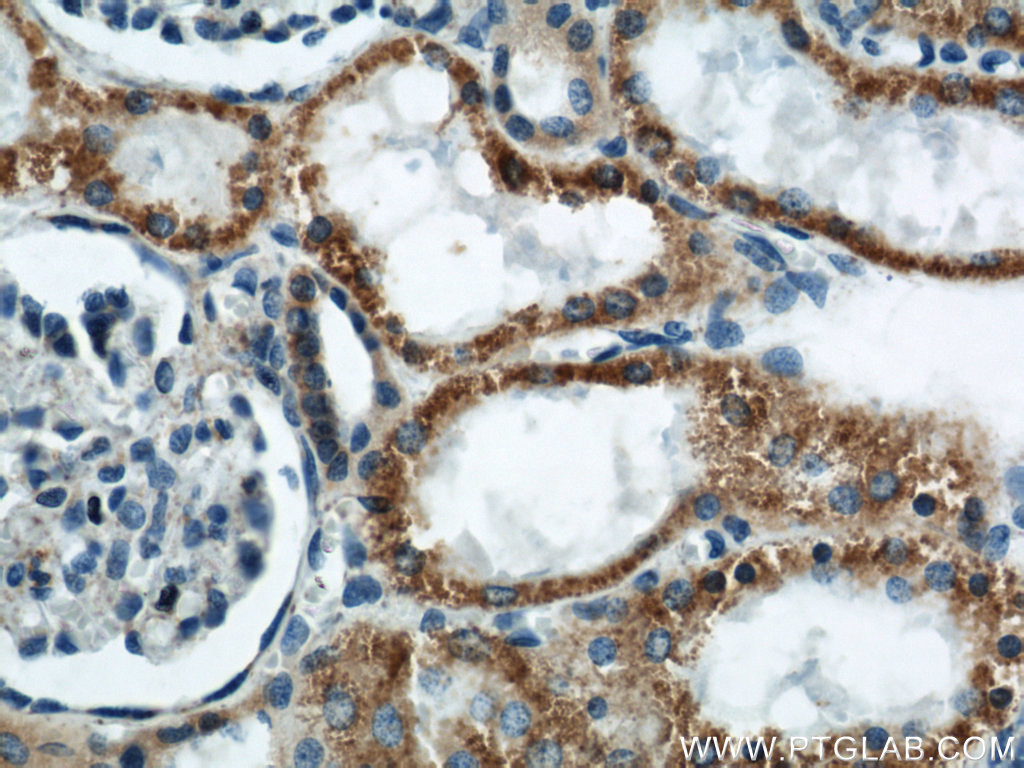

验证数据展示
经过测试的应用
| Positive WB detected in | human plasma tissue |
| Positive IP detected in | human plasma tissue |
| Positive IHC detected in | human liver tissue, human kidney tissue Note: suggested antigen retrieval with TE buffer pH 9.0; (*) Alternatively, antigen retrieval may be performed with citrate buffer pH 6.0 |
| Positive IF/ICC detected in | HepG2 cells |
推荐稀释比
| 应用 | 推荐稀释比 |
|---|---|
| Western Blot (WB) | WB : 1:20000-1:100000 |
| Immunoprecipitation (IP) | IP : 0.5-4.0 ug for 1.0-3.0 mg of total protein lysate |
| Immunohistochemistry (IHC) | IHC : 1:500-1:5000 |
| Immunofluorescence (IF)/ICC | IF/ICC : 1:200-1:800 |
| It is recommended that this reagent should be titrated in each testing system to obtain optimal results. | |
| Sample-dependent, Check data in validation data gallery. | |
产品信息
66124-1-Ig targets APOL1-Specific in WB, IHC, IF/ICC, IP, ELISA applications and shows reactivity with human samples.
| 经测试应用 | WB, IHC, IF/ICC, IP, ELISA Application Description |
| 文献引用应用 | WB, IHC, IF, IP |
| 经测试反应性 | human |
| 文献引用反应性 | human |
| 免疫原 |
CatNo: Ag2016 Product name: Recombinant human APOL1 protein Source: e coli.-derived, PGEX-4T Tag: GST Domain: 1-238 aa of BC017331 Sequence: MEGAALLRVSVLCIWMSALFLGVGVRAEEAGARVQQNVPSGTDTGDPQSKPLGDWAAGTMDPESSIFIEDAIKYFKEKVSTQNLLLLLTDNEAWNGFVAAAELPRNEADELRKALDNLARQMIMKDKNWHDKGQQYRNWFLKEFPRLKSELEDNIRRLRALADGVQKVHKGTTIANVVSGSLSISSGILTLVGMGLAPFTEGGSLVLLEPGMELGITAALTGITSSTMDYGKKWWTQA 种属同源性预测 |
| 宿主/亚型 | Mouse / IgG2a |
| 抗体类别 | Monoclonal |
| 产品类型 | Antibody |
| 全称 | apolipoprotein L, 1 |
| 别名 | APOL1, 1G12D11, Apo-L, ApoL-I, Apolipoprotein L I |
| 计算分子量 | 44 kDa |
| 观测分子量 | 39-45 kDa |
| GenBank蛋白编号 | BC017331 |
| 基因名称 | APOL1 |
| Gene ID (NCBI) | 8542 |
| RRID | AB_2881523 |
| 偶联类型 | Unconjugated |
| 形式 | Liquid |
| 纯化方式 | Protein A purification |
| UNIPROT ID | O14791 |
| 储存缓冲液 | PBS with 0.02% sodium azide and 50% glycerol, pH 7.3. |
| 储存条件 | Store at -20°C. Stable for one year after shipment. Aliquoting is unnecessary for -20oC storage. |
背景介绍
Human apolipo-protein L1 (APOL1) is a minor component of plasma high density lipoprotein (HDL) particles, acting as an interacting protein of apolipoprotein A1 (ApoA1). The human ApoL protein family was thought to be predominantly involved in lipid transport and metabolism. APOL1 is also involved in host innate immunity against Trypanosoma parasites. Once activated, APOL1 can lyse the parasite and protect human from infection. Genetic variants in APOL1 gene, which are found in African ancestry with high frequency, associate with chronic kidney disease, like focal segmental glomerulosclerosis (FSGS), HIV-associated nephropathy (HIVAN), and hypertensive nephropathy. APOL1 share structural and functional similarities with proteins of the Bcl-2 family and may has roles in apoptosis and autophagy. It is notable that APOL1 exists only in human and a few other primate species, and mouse does not express an APOL1 orthologue. This antibody recognizes the endogenous ApoL1 of 39-45 kDa in blood lysate. This antibody is specific to APOL1.
实验方案
| Product Specific Protocols | |
|---|---|
| IF protocol for APOL1-Specific antibody 66124-1-Ig | Download protocol |
| IHC protocol for APOL1-Specific antibody 66124-1-Ig | Download protocol |
| IP protocol for APOL1-Specific antibody 66124-1-Ig | Download protocol |
| WB protocol for APOL1-Specific antibody 66124-1-Ig | Download protocol |
| Standard Protocols | |
|---|---|
| Click here to view our Standard Protocols |
发表文章
| Species | Application | Title |
|---|---|---|
Immunity APOL1 risk variants in individuals of African genetic ancestry drive endothelial cell defects that exacerbate sepsis. | ||
J Am Soc Nephrol Kidney Disease-Associated APOL1 Variants Have Dose-Dependent, Dominant Toxic Gain-of-Function. | ||
Mol Ther Antisense oligonucleotides ameliorate kidney dysfunction in podocyte-specific APOL1 risk variant mice. | ||
Elife Apolipoprotein L-1 renal risk variants form active channels at the plasma membrane driving cytotoxicity. | ||